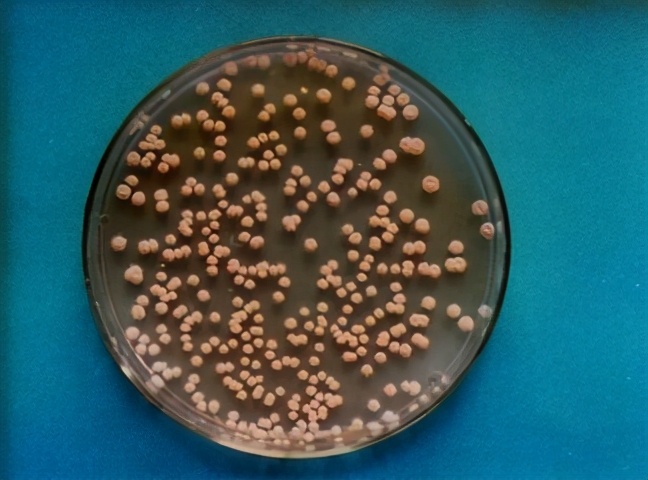
臭氧消灭螨虫的方法,室内除螨虫最有效方法

卧室,是人们日常生活休息和睡眠的重要场所,从清晨到夜晚,这个空间为人们提供的是轻松和舒适,但却也是细菌、微生物繁殖最为旺盛的空间之一。特别是冬季气温低,开窗通风很多家庭是做不到,北方供暖的卧室更是不可能,卧室的环境就变得更糟糕。

德国慕尼黑大学研究组曾针对卧室内的微生物和细菌做过一项抽样测试,在随机抽取的10个家庭卧室中,研究人员发现了大量的支原体、葡萄球菌、大肠杆菌、霉菌,甚至还有轮状病毒。
1.支原体
支原体广泛分布于卧室中人可接触到的一切地方,包括地板、床单、床头柜、台灯按钮、门把手,是卧室最多的有害微生物。支原体是目前发现的最小的细菌,直径在100纳米到300纳米之间。肺炎支原体是其中常见的支原体,它是我们熟知的非典型肺炎的主要病原体。

2.葡萄球菌
葡萄球菌也是广泛繁殖于我们卧室的另一类微生物,它们中最常见的是表皮葡萄球菌和金黄色葡萄球菌。它们主要滋生于身体接触比较多的地方,例如枕头、门把手、遥控器、床单等等。膜状结构的表皮葡萄球菌对抗生素和免疫系统有很高的耐受力,因此很难被清除。

3.灰尘
卧室里的灰尘中有许多人体的代谢废物如头发、皮屑等等。这其中富含的无机物和有机物为细菌的滋生提供了绝佳的场所。房间中每1克灰尘最多可以含有500到1000种、近1亿的细菌,包括上述的葡萄球菌以及棒状杆菌、乳球菌、尘螨等等。灰尘中细菌的种类有很大的变异性,与卫生习惯、居住环境等密切相关,比如宠物活动就能极大地改变卧室灰尘的菌落组成。因此,对于有宠物的家庭来说,适当的定期除尘尤为重要。

4.霉菌
霉菌可能是大家最为熟知的微生物,这是一大类能引起食物霉变的真菌的统称。在卧室里,霉菌主要由鞋底带入。配置卧室专用拖鞋并定期清洗更换能有效地减少霉菌的污染。霉菌喜欢潮湿温暖的生长环境,南方的梅雨季节是其最爱。霉菌会使衣服、家具、被褥等发霉,产生霉斑,对人体健康也有危害,容易造成皮肤感染。
5.轮状病毒
在卧室中,最为低等的微生物非病毒莫属。卧室里常见的轮状病毒就可以在环境中存活许多天,主要存在于人手接触物的表面,遥控器、鼠标、门把手是其重灾区。感染轮状病毒主要的症状就是腹泻,对婴幼儿的影响尤为严重,全世界每年有超过50万5岁以下的儿童因感染轮状病毒而死亡,因此对幼童的卧室一定要注意定期的卫生消毒。

在枕头、床单、被罩表面,除了人体日常所代谢的表皮皮屑、长期使用堆积的螨虫以外,空气中的灰尘也广泛存在于床上用品表面,这无形成为了影响人们身体健康的安全隐患。除此之外,卧室的窗帘、床头柜、地毯、床底等角落,不仅极易堆积大量灰尘,更为细菌的繁殖滋生创造了绝佳的条件。卧室作为人们生活重要的场所,内部环境的洁净度会直接影响人们的身体健康。皮肤科专家表示,80%的面部肌肤问题,如*疮痤**、痘痘等,都是由于面部长期接触带有细菌、螨虫的枕头或毛巾所导致。

那么,清理卧室内的有害细菌,究竟应该怎么做呢?超氧(臭氧)消毒作用多,可以满足卧室除菌除螨的需求。
超氧(臭氧)是氧气的同素异形体,具有强氧化性。超氧(臭氧)以氧原子的氧化作用破坏微生物膜的结构,以实现杀菌作用。超氧(臭氧)对细菌的灭活反应总是进行得很迅速,与其它杀菌剂不同的是:超氧(臭氧)能与细菌细胞壁之类的双键反应,穿入菌体内部,作用于蛋白和脂多糖,改变细胞的通透性,从而导致细菌死亡。

超氧(臭氧)杀菌种类多,光谱高效,灭杀的细菌病毒种类有细菌繁殖体,如大肠杆菌、金黄色葡萄球菌、霉菌、真菌、念珠菌。对大肠杆菌和金黄色葡萄球菌的杀灭率均达100%。
有病毒,如30分钟,10.3mg/m³乙型肝炎表面抗原,13.6mg/m³甲型肝炎病毒,0.5ppm甲型流感病毒,0.13mg/m³灭杀脊髓灰质病毒。0.09--0.8mg/L噬菌体。0.25mg/L源轮状病毒。

真菌:对杂色曲霉、桃色拟毒霉、腊叶枝孢霉、青霉菌、黑曲霉等有效。原虫:对鞭毛虫、隐孢子虫卵有效。孢囊:在超氧(臭氧)浓度为0.3 mg/L下作用2.4 min就被完全除掉。孢子:由于孢衣的保护,它比生长态菌的抗超氧(臭氧)能力高出10 - 15倍。寄生生物:如螨虫在3 min后被杀灭。
可以说,超氧(臭氧)对卧室中支原体、葡萄球菌、尘螨、霉菌、轮状病毒等微生物都有明显的杀灭作用,在相对湿度≥60%条件下,采用20mg/m3浓度的超氧(臭氧)进行消毒,消毒时间应≥30min,基本上可以保证把卧室内的各种细菌病毒灭杀殆尽。

由于超氧(臭氧)浓度过高时有一定刺激性,所以使用超氧(臭氧)消毒除菌时人员不能待在卧室内。超氧(臭氧)是有半衰期的,15--30分钟就可以自动分解成氧气,无残留无二次污染,还能增加卧室的氧含量,卧室的空气变得更加新鲜。

卧室里滋生的细菌都是随人而来。我们的落发、皮屑、汗渍等富含各种有机物和无机物,滞留于卧室中最常接触的床、地板、还是门把手上,为微生物的存活提供了理想的环境。因此,十分有必要在卧室使用超氧(臭氧)来除菌去螨虫,消除卧室微生物对身体健康的威胁。